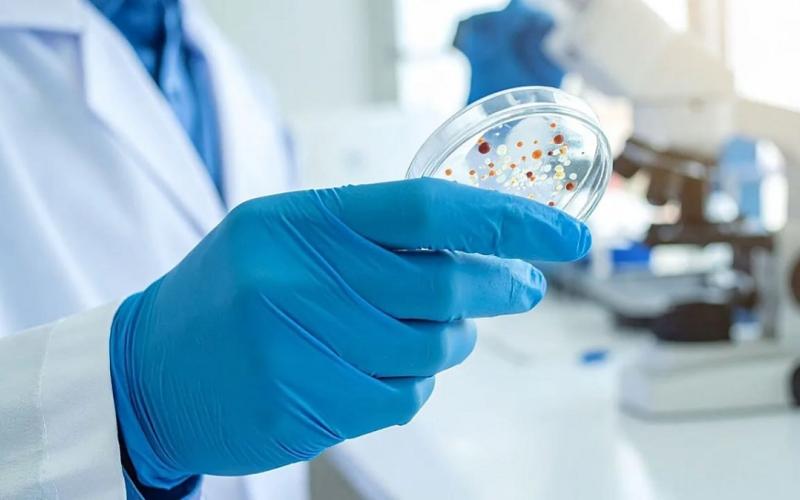
هوش مصنوعی

بررسی مقاومت ابرباکتریها در برابر هوش مصنوعی
مقاومت ضدمیکروبی یکی از بزرگترین چالشهایی است که با آن در خدمات ملی سلامت در جهان روبهرو هستیم و به همین منظور دانشمندان در بریتانیا تصمیم گرفته اند از هوش مصنوعی برای مقابله با تهدید فزاینده عفونتهایی که در برابر درمان مقاوم شدهاند، استفاده کنند.
به گزارش سیتنا، دانشمندان در بریتانیا بهزودی از هوش مصنوعی برای مقابله با تهدید فزایندهِ عفونتهایی که در برابر درمان مقاوم شدهاند استفاده خواهند کرد.
مقاومت ضدمیکروبی (AMR) زمانی رخ میدهد که عوامل بیماریزا مانند باکتریها یا ویروسها آنقدر تکامل پیدا میکنند که از اثر داروهای موجود میگریزند و درمان عفونتها دشوارتر میشود. استفاده بیش از حد از آنتیبیوتیکها در حوزه سلامت و کشاورزی این روند را سرعت میبخشد.
برآوردها نشان میدهد اکنون حدود یک مورد از هر شش عفونت باکتریاییِ تأییدشده در آزمایشگاه نسبت به آنتیبیوتیکها مقاوم است، دادههای جهانی نشان میدهد، و انتظار میرود مقاومت ضدمیکروبی تا سال ۲۰۵۰ بهطور مستقیم جان ۳۹ میلیون نفر را بگیرد.
این خطرها دانشمندان را به تلاش شتابان برای توسعه داروهای تازه واداشته است. اکنون نیز آنها روی هوش مصنوعی حساب باز کردهاند تا به این جستوجو کمک کند.
حدود ۵۰ پژوهشگر روی ابتکاری سهساله کار خواهند کرد که اوایل سال آینده با ۴۵ میلیون پوند (۵۱ میلیون یورو) از سوی غول داروسازی GSK آغاز میشود. این شرکت برای اجرای این برنامه با «ابتکار فلمینگ»، گروهی بریتانیایی که دانشمندان، سیاستگذاران و فعالان صنعت سلامت را گرد هم میآورد، همکاری کرده است.
«مقاومت ضدمیکروبی یکی از بزرگترین چالشهایی است که با آن در [خدمات ملی سلامت] و در سراسر جهان روبهرو هستیم»، تیم اورچرد، مدیرعامل «Imperial College Healthcare NHS Trust» که در اجرای ابتکار فلمینگ مشارکت دارد، گفت.
اورچرد در بیانیهای افزود: «درمان عفونتهای مقاوم به دارو هر روز دشوارتر میشود و این عفونتها خطری فزاینده برای بیماران ایجاد میکنند».
پژوهشگران بر چند عامل بیماریزای مقاوم به دارو تمرکز خواهند کرد که سازمان جهانی بهداشت (WHO) آنها را بهعنوان پاتوژنهای اولویتدار شناسایی کرده است: آسپرژیلوس، باکتریهای گرممنفی مانند اشریشیا کولی (E. coli) و کلبسیلا پنومونیه، و استافیلوکوک اورئوس، از جمله نوع مقاوم به متیسیلین آن (MRSA).
در یکی از پروژهها، آنها یک مدل هوش مصنوعی ایجاد خواهند کرد تا آنتیبیوتیکهای تازه را برای مقابله با عفونتهای گرممنفیِ مقاوم به چند دارو طراحی و آزمون کند. GSK اعلام کرد دادهها و مدلهای هوش مصنوعی در اختیار دانشمندان در نقاط دیگر جهان قرار خواهد گرفت تا توسعه درمانهای نسل بعدی شتاب بگیرد.
گروه دیگری از هوش مصنوعی بهره میبرد تا بهتر بفهمد دستگاه ایمنی چگونه به S. aureus پاسخ میدهد تا دانشمندان بتوانند واکسنی مؤثر علیه این عفونتها بسازند.
اورچرد گفت: «برای مقابله با عفونتهای مقاوم به دارو فوراً به راهحلها و مداخلات تازه نیاز داریم؛ دستیابی به این هدف تنها زمانی ممکن است که دانش و تخصص خود را یکجا بگذاریم».
انتهای پیام

افزودن دیدگاه جدید